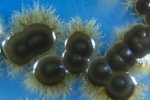
Бытовая техника способна убить человека, установили биологи

Тег: Установили

На Ставрополье установили мемориал «Воинам необъявленных войн»
В селе Николина Балка Петровского района состоялось торжественное открытие мемориала «Воинам необъявленных войн», сообщает пресс-служба ГУ МВД России...

В парке Победы Ставрополя установили новый экстремальный аттракцион
В парке Победы краевого центра к очередному летнему сезону построили новый экстремальный аттракцион «Циклон». Как сообщает администрация парка, он изг...

В столице СКФО установили 12-метровую новогоднюю ель
На площади перед администрацией города Пятигорска в преддверии праздника установили 12-метровую новогоднюю ель. К разработке дизайна новогодней елки...

Эксперты установили, почему чихающий и кашляющий человек столь опасен
Оказывается, на небе располагаются целые колонии вируса гриппа. Итак, мягкие ткани, которые отделяют заднюю часть ротовой полости и полости носа, очен...

На Ставрополье установили патриотический рекорд
На Ставрополье создана самая большая копия Знамени Победы. Площадь полотнища составляет 700 квадратных метров.Проект реализован силами кадетов Ставроп...

В Ставрополе в одном из подземных переходов установили электроподъёмник для инвалидов-колясочников
На площади 200-летия краевого центра Андрей Джатдоев и Иван Ульянченко вместе с председателем Ставропольского городского общества инвалидов Михаилом Ч...

На Ставрополье установили поклонный крест в память о погибших на Украине
В Новоалександровском районе накануне был открыт поклонный крест в память о погибших в результате конфликта на Украине. Крест установлен в знак благо...

В ставропольском парке Победы установили памятник велосипеду
В парке Победы, на площадке между фонтаном и «Скамьей примирения», установили «Первый велосипед». Новый арт-объект городу подарил Ставропольский музей...

Новый комплекс фиксации нарушений ПДД установили в Ставрополе
На одном из аварийно опасных участков в Ставрополе - перед перекрёстком улиц Лермонтова и Ломоносова - установлен новый комплекс видеофиксации нарушен...

Во Дворце детского творчества установили олимпийский факел
В холле первого этажа Ставропольского Дворца детского творчества почетное место занял олимпийский факел Зимних Олимпийских игр в городе Сочи...

Медики установили возможную причину развития эндометриоза
Много женщин во всем мире страдают от эндометриоза, но до сих пор врачи не знают, что именно вызывает это расстройство. Массачусетский технологически...

Ученые Оклендского университета в Новой Зеландии установили, что прием витамина D после 50 лет практически ничего не дает
Витамин D обычно назначают людям после 50 лет в качестве профилактики остеопороза. Но австралийские ученые выяснили, что добавки с витамином D не улу...

Ставропольские пловцы установили новые рекорды на чемпионате и кубке России
Воспитанники ДЮСШОР №2 успешно выступили на соревнованиях чемпионата и кубка России по плаванию. При поддержке администрации города они выступили в со...

Мировые эксперты установили новые нормы по потреблению соли
Глобальная организация здравоохранения в первый раз выпустила советы по потреблению соли для деток, передает Reuters. Знаменито, что завышенный урове...

Проверяющие установили факт обмана на заправке
Сотрудники прокуратуры по поручению прокурора края с привлечением профессионалов ФБУ «Муниципальный региональный центр стандартизации, метрологии и ис...

Голландцы установили рекорд в первый день Нового года
Обитатели Голландии с размахом отметили приход Новейшего 2012 года. Им удалось установить истинный рекорд, ведь в 1-ый день года необыкновенное количе...

Материализм - серьезная помеха браку, установили психологи
К такому выводу пришли ученые в ходе исследования, появившегося на страничках журнальчика American Journal of Couple & Relationship Therapy, извещает...

В Беломечетской установили поклонный крест в память о погибших омоновцах
В станице Беломечетская отслужили панихиду и установили поклонный крест в память о сотрудниках милиции, погибших в перестрелке с боевиками в феврале э...

Жители Японии установили новый рекорд долгожительства
Согласно последнему исследованию, в текущем году японки остаются на первом месте в списке долгожителей, хотя их средняя продолжительность жизни и немн...

Пациенты клиник пластической хирургии страдают дисморфофобией, установили ученые
Исследователи Университетского госпиталя Левена в Бельгии уверены: люди, желающие сделать себе пластическую операцию, на самом деле, страдают от дисмо...

Чувствительная кожа и рак связаны, установили специалисты
Датские ученые заявляют: между некоторыми типами рака и кожной аллергией есть связь. Они специально следили за 17000 датчанами, которые проходили тест...

Питательный напиток оказался более опасным, чем пончики, установили эксперты
Напиток, который призван быть полезным дополнением к рациону человека за счет витаминов, минеральных веществ и родниковой воды, как выяснилось, содерж...

Детям военнослужащих грозят психические расстройства, установили психологи
Чем дольше американские солдаты служат в Ираке или Афганистане, тем больше вероятность того, что у их детей разовьются психические отклонения, выяснил...
Бытовая техника способна убить человека, установили биологи
Посудомоечные машины являются рассадником смертельно опасных организмов. Влажная и теплая среда – идеальные условия для двух видов грибка, которые так...

На Ставрополье установили предельные цены на противовирусные средства
Сотрудники министерства здравоохранения Ставропольского края проанализировали фармацевтический рынок региона на наличие противовирусных препаратов...